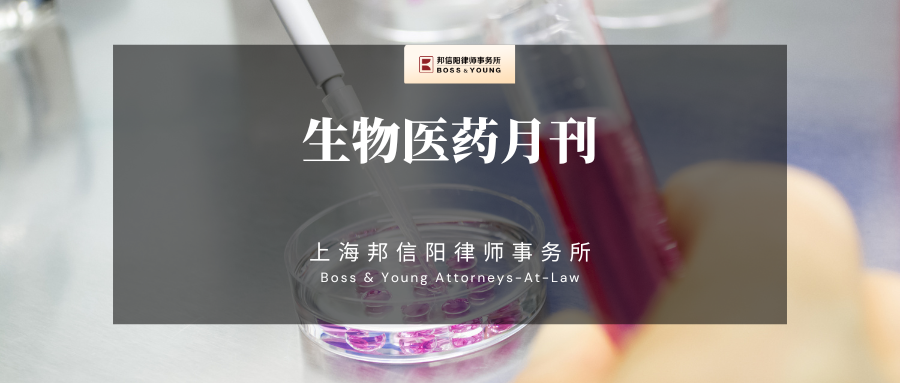

目录
一、法规及政策
(一)风向动态
(2023年11月8日)国务院常务会议审议通过了《专利法实施细则(修正草案)》
(2023年11月30日)最高人民法院关于审理食品药品惩罚性赔偿纠纷案件适用法律若干问题的解释
(二)国家新规
(2023年11月3日)国家药监局关于发布《药物临床试验机构监督检查办法(试行)》的通告
(2023年11月6日)国家药监局综合司公开征求《麻醉药品和精神药品实验研究管理规定(征求意见稿)》意见
(2023年11月10日)国家药监局关于化妆品新原料鼓励创新和规范管理有关事宜的公告
(2023年11月17日)关于党参等9种新增按照传统既是食品又是中药材的物质公告
(2023年11月23日)国家医疗保障局办公室关于加强和改进医药价格和招采信用评价工作的通知
(2023年11月24日)国家药监局关于发布YY0315—2023《钛及钛合金牙种植体》等13项医疗器械行业标准及7项医疗器械行业标准修改单的公告
(2023年11月28日)国家药监局综合司公开征求《医疗器械临床试验检查要点及判定原则(征求意见稿)》意见
(三)地方新规
(2023年11月8日)安徽省药品监督管理局关于发布实施《安徽省中药材标准》(2022年版)
(2023年11月10日)关于《江苏省药品安全责任约谈管理办法(征求意见稿)》公开征求意见的公告
(2023年11月10日)关于《江苏省药品监督管理行政处罚裁量权适用规则(修订草案征求意见稿)》公开征求意见的公告
(2023年11月20日)关于印发《上海市遏制微生物耐药行动计划(2022-2025年)实施方案》的通知
二、生物医药案例
【国外】美国倍而达公司起诉益方生物侵犯化合物商业秘密
【国外】生物医药公司NanoString Technologies侵犯Prognosys公司的专利
【国外】英国法院驳回雅培针对德康医疗专利侵权诉讼
【国外】美国生物制药公司再生元起诉Celltrion专利侵权
【国外】艾伯维向5家生物类似药生产商起诉Rinvoq专利权侵权
【国外】欧洲专利局撤销美国生物技术公司Moderna一项专利
一、法规及政策
(一)风向动态
1.(2023年11月8日)国务院常务会议审议通过了《专利法实施细则(修正草案)》
国务院常务会议审议通过《中华人民共和国专利法实施细则(修正草案)》,此次细则修改有三个方面特点:一是贯彻落实党中央、国务院关于加强知识产权保护的决策部署,进一步提升我国专利创造、运用、保护、管理和服务水平。二是依照修改后的专利法细化、完善相关制度,维护专利制度的一致性、稳定性。三是与加入的相关国际条约做好衔接,积极落实国际条约义务、进一步融入国际规则。
具体而言,修改主要涉及五个方面:一是完善专利申请制度,便利申请人和创新主体;二是完善专利审查制度,提高专利审查质量;三是加强专利行政保护,维护专利权人合法权益;四是加强专利公共服务,促进专利转化运用;五是新增外观设计国际申请特别规定,加强与海牙协定的衔接。
来源:国务院官方网站
https://www.gov.cn/zhengce/202311/content_6914243.htm
2.(2023年11月30日)最高人民法院关于审理食品药品惩罚性赔偿纠纷案件适用法律若干问题的解释
为正确审理食品药品惩罚性赔偿纠纷案件,根据《中华人民共和国民法典》《中华人民共和国消费者权益保护法》《中华人民共和国食品安全法》《中华人民共和国药品管理法》等法律规定,结合审判实践,本院起草了《最高人民法院关于审理食品药品惩罚性赔偿纠纷案件适用法律若干问题的解释(征求意见稿)》。为广泛听取社会各界意见,更好回应人民群众关切,服务保障社会经济高质量发展,现通过最高人民法院政务网、中国法院网、人民法院报等向社会公开征求意见。
最高人民法院
关于审理食品药品惩罚性赔偿纠纷案件适用法律若干问题的解释(征求意见稿)
为正确审理食品药品惩罚性赔偿纠纷案件,根据《中华人民共和国民法典》《中华人民共和国消费者权益保护法》《中华人民共和国食品安全法》《中华人民共和国药品管理法》等法律规定,结合审判实践,制定本解释。
第一条 【退款和返还食品药品】知道所购买食品不符合食品安全标准或者药品是假药、劣药仍然购买,购买者请求经营者返还价款的,人民法院应当依法支持。
经营者请求购买者返还食品、药品的,人民法院应当依法支持。返还食品、药品依法不能再次销售的,人民法院可以在裁判文书中说明。
第二条 【惩罚性赔偿金基数认定】知道所购买食品不符合食品安全标准仍然购买,购买者依据食品安全法第一百四十八条第二款规定请求生产者或者经营者支付价款十倍的惩罚性赔偿金的,人民法院应当在合理生活消费需要范围内依法支持购买者诉讼请求。
人民法院可以综合保质期、普通消费者通常消费习惯等因素认定购买者合理生活消费需要的食品数量。
第三条 【对连续购买索赔的规范】知道所购买食品不符合食品安全标准仍然在短时间内多次购买,购买者依据食品安全法第一百四十八条第二款规定起诉请求同一生产者或者经营者支付惩罚性赔偿金,并主张按每次购买金额分别计算惩罚性赔偿金的,人民法院可以将购买者短时间内多次购买相同食品的付款总额作为计算惩罚性赔偿金的基数,在合理生活消费需要范围内依法支持购买者诉讼请求。
第四条 【对反复索赔的规范】
方案一:知道所购买食品不符合食品安全标准仍然在短时间内多次购买,并多次依据食品安全法第一百四十八条第二款规定就同一不符合食品安全标准的食品起诉请求同一生产者或者经营者支付惩罚性赔偿金的,人民法院应当在合理生活消费需要范围内对购买者第一次起诉请求支付惩罚性赔偿金的诉讼请求依法予以支持。
方案二:删除本条规定。
第五条 【假药劣药认定的特殊情形】存在下列情形之一,购买者依据药品管理法第一百四十四条第三款规定请求生产者或者经营者支付惩罚性赔偿金的,人民法院不予支持:
(一)不以营利为目的实施带有自救、互助性质的生产、销售少量药品行为,且未造成他人伤害后果或者延误诊治的;
(二)不以营利为目的实施带有自救、互助性质的进口少量境外合法上市药品行为的;
(三)根据民间传统配方私自加工药品或者销售上述药品,数量不大,且未造成他人伤害后果或者延误诊治的。
对于是否属于民间传统配方难以确定的,根据地市级以上药品监督管理部门或者有关部门出具的认定意见,结合其他证据作出认定。
证据证明生产假药、劣药或者明知是假药、劣药仍然销售、使用的,不适用本条第一款规定。
第六条 【食品标签说明书瑕疵的认定】人民法院在认定食品安全法第一百四十八条第二款规定的食品的标签、说明书瑕疵时,应当根据消费者在购买食品时的主观状态认定标签、说明书瑕疵是否会对消费者造成误导,并结合食品安全法第一百五十条关于食品安全的规定,对标签、说明书瑕疵是否影响食品安全作出认定。
第七条 【食品标签说明书瑕疵的表现形式】人民法院可以认定下列情形属于食品安全法第一百四十八条第二款规定的食品的标签、说明书瑕疵:
(一)文字、符号、数字的字号、字体、字高不规范,或者外文字号、字高大于中文的;
(二)出现错别字、多字、漏字、繁体字或者外文翻译不准确,但不会导致消费者对食品安全产生误解的;
(三)净含量、规格的标示方式和格式不规范,食品、食品添加剂以及配料使用的俗称或者简称等不规范,营养成分表、配料表顺序、数值、单位标示不规范,或者营养成分表数值修约间隔、“0”界限值、标示单位不规范,但不会导致消费者对食品安全产生误解的;
(四)对没有特殊贮存条件要求的食品,未按照规定标注贮存条件的;
(五)食品的标签、说明书存在其他瑕疵,但不影响食品安全且不会对消费者造成误导的。
第八条 【不属于食品标签说明书瑕疵的情形】人民法院应认定下列情形不属于食品安全法第一百四十八条第二款规定的食品的标签、说明书瑕疵:
(一)未标明食品安全标准要求必须标明的事项的;
(二)故意错标食品安全标准要求必须标明的事项的;
(三)未正确标明食品安全标准要求必须标明的事项,足以导致消费者对食品安全产生误解的。
第九条 【惩罚性赔偿责任的竞合】经营明知是不符合食品安全标准的食品或者假药、劣药,经营行为同时构成欺诈,购买者选择依据食品安全法第一百四十八条第二款、药品管理法第一百四十四条第三款或者消费者权益保护法第五十五条第一款规定起诉请求经营者承担惩罚性赔偿责任的,人民法院应当依法支持。
购买者依据食品安全法第一百四十八条第二款或者药品管理法第一百四十四条第三款规定起诉请求经营者承担惩罚性赔偿责任,人民法院经审理认为购买者诉讼请求不成立但经营者行为构成欺诈,经释明后购买者变更诉讼请求为依据消费者权益保护法第五十五条第一款规定请求经营者承担惩罚性赔偿责任的,人民法院应当准许并可以根据案件的具体情况重新指定举证期限。
第十条 【小作坊等生产经营食品的责任】食品生产加工小作坊和食品摊贩等生产经营的食品不符合食品安全标准,购买者请求生产者或者经营者依据食品安全法第一百四十八条第二款规定承担惩罚性赔偿责任的,人民法院应当依法支持。
食品生产加工小作坊和食品摊贩等生产经营的食品虽不符合省、自治区、直辖市制定的具体管理办法等规定,但不存在不符合食品安全标准的情形,购买者请求生产者或者经营者依据食品安全法第一百四十八条第二款规定承担惩罚性赔偿责任的,人民法院不予支持。
第十一条 【以食品自身的安全标准作为认定惩罚性赔偿责任的依据】人民法院认定食品安全法第一百四十八条第二款规定的不符合食品安全标准的食品时,应当以食品中危害人体健康物质的限量规定、特定人群的主辅食品的营养成分要求、与食品安全有关的质量要求以及对与卫生、营养等食品安全要求有关的标签、标志、说明书的要求等食品安全标准为依据。
第十二条 【代购责任】受托人受购买者委托购买其指定的食品、药品,购买者依据食品安全法第一百四十八条第二款或者药品管理法第一百四十四条第三款规定请求受托人承担惩罚性赔偿责任的,人民法院不予支持,但受托人以代购为业且明知是不符合食品安全标准的食品或者假药、劣药仍然代购的除外。
第十三条 【恶意索赔的惩治】购买者通过私藏食品、私放过期食品、伪造标签等方式恶意制造生产者或者经营者违法生产经营食品、药品的虚假事实,起诉请求生产者或者经营者承担赔偿责任的,人民法院应当驳回原告诉讼请求。
原告行为构成虚假诉讼的,人民法院应当依据民事诉讼法相关规定,根据情节轻重对其处以罚款、拘留。
原告行为损害生产者或者经营者的名誉权等权利,生产者或者经营者请求原告承担损害赔偿责任的,人民法院应当依法支持。
第十四条 【犯罪线索移送】人民法院在审理食品药品纠纷案件过程中,发现涉嫌生产、销售有毒、有害食品,敲诈勒索,虚假诉讼等犯罪的,应当及时将有关线索、材料移送公安机关。
第十五条 【司法建议】人民法院在审理食品药品纠纷案件过程中,发现生产、销售有毒、有害食品等违法生产经营食品药品行为的,可以就召回食品药品、实施行政处罚、停止违法行为等向有关行政机关、生产者或者经营者发出司法建议。
第十六条 【附则】本解释自 年 月 日起施行。
来源:中国法院网
https://www.chinacourt.org/article/detail/2023/11/id/7665508.shtml
(二)国家新规
1.(2023年11月3日)国家药监局关于发布《药物临床试验机构监督检查办法(试行)》的通告
为进一步加强对药物临床试验机构的管理,规范药物临床试验机构监督检查工作,国家药监局组织制定了《药物临床试验机构监督检查办法(试行)》,现予发布。本通告自2024年3月1日起实施。
药品监督管理部门对药物临床试验机构备案及开展以药品注册为目的的药物临床试验活动遵守相关法律法规、执行GCP等情况实施检查、处置等,适用本办法。
来源:国家药监局官方网站
https://www.nmpa.gov.cn/xxgk/fgwj/xzhgfxwj/20231103175749117.html
2.(2023年11月6日)国家药监局综合司公开征求《麻醉药品和精神药品实验研究管理规定(征求意见稿)》意见
为贯彻落实《药品管理法》《麻醉药品和精神药品管理条例》,进一步规范麻醉药品和精神药品实验研究,国家药监局组织对《关于麻醉药品和精神药品实验研究管理规定的通知》(国食药监安〔2005〕529号)进行了修订,形成《麻醉药品和精神药品实验研究管理规定(征求意见稿)》,现向社会公开征求意见。
开展麻醉药品和精神药品实验研究前应提出立项申请并获得批准。本规定所称实验研究是指在中华人民共和国境内以药品注册为目的,在药品注册申请前开展的药物临床前研究活动。
有下列情形之一的,应当按照本规定提出申请:
(一)开展麻醉药品和精神药品(包括原料药、单方制剂和复方制剂,下同)实验研究的;
(二)开展境外生产麻醉药品和精神药品境内注册的;
(三)开展麻醉药品药用原植物来源药品实验研究的;
(四)开展境外已上市境内未上市,在境内未列管为麻醉药品和精神药品,在已上市国家或地区按照麻醉药品和精神药品管制药品实验研究的;
(五)开展尚未列入麻醉药品和精神药品目录但具有依赖性潜力药物实验研究的;
(六)国家药品监督管理局规定的其他情形。
来源:国家药监局官方网站
https://www.nmpa.gov.cn/xxgk/zhqyj/zhqyjyp/20231106165607164.html
3.(2023年11月10日)国家药监局关于化妆品新原料鼓励创新和规范管理有关事宜的公告
化妆品新原料研究创新是化妆品技术创新的基础,化妆品新原料安全是产品质量安全的源头。国家药监局持续推进化妆品新原料技术支撑体系建设,组织相关技术部门研究建立化妆品新原料沟通交流机制,加快化妆品新原料研究技术指导原则制修订,加强化妆品新原料注册备案的技术指导服务。
化妆品新原料注册人、备案人作为新原料质量安全和安全监测的责任主体,应当加强新原料研究、生产和使用过程的规范管理,确保新原料注册备案资料及数据的真实性、科学性和可追溯性,对新原料在化妆品中的正确使用和安全监测持续进行跟踪,确保新原料和关联产品质量安全。
加强化妆品新原料全链条安全风险评估与防控,确保使用新原料的化妆品的质量安全。药品监督管理部门应当按照相关法律法规、技术规范要求,强化新原料和相关产品的监督管理,加强对化妆品新原料注册备案管理、使用和安全情况的监测评估,督促企业主体责任落实到位。
来源:国家药监局官方网站
https://www.nmpa.gov.cn/xxgk/ggtg/hzhpggtg/jmhzhptg/20231110101336138.html
4.(2023年11月17日)关于党参等9种新增按照传统既是食品又是中药材的物质公告
根据《中华人民共和国食品安全法》及其实施条例、《按照传统既是食品又是中药材的物质目录管理规定》,经安全性评估及试点生产经营,现将党参、肉苁蓉(荒漠)、铁皮石斛、西洋参、黄芪、灵芝、山茱萸、天麻、杜仲叶等9种物质纳入按照传统既是食品又是中药材的物质目录。
来源:国家卫健委官方网站
http://www.nhc.gov.cn/sps/s7892/202311/f0d6ef3033b54333a882e3d009ff49bf.shtml
5.(2023年11月23日)国家医疗保障局办公室关于加强和改进医药价格和招采信用评价工作的通知
各省、自治区、直辖市及新疆生产建设兵团医疗保障局,医药集中采购机构:
医药价格和招采信用评价(以下简称“价格招采信用评价”)制度实施以来,在营造公平公正的医药采购交易环境、推动医药企业诚信经营、维护规范的药品耗材价格秩序等方面发挥了积极作用,但也存在向生产企业穿透不到位、失信处置不及时等问题。为进一步压实责任、强化制度落实,现就有关事项通知如下。
一、强化责任担当
各省级医药集采机构要切实承担价格招采信用评价工作实施主体责任,在准确把握运用裁量基准和操作规范的基础上,积极推进失信评级处置工作,原则上在接到国家医保局通报相关案源6个月内完成评级处置。各省级医疗保障部门要切实履行对省级医药集采机构评级处置的指导和监督职责,对工作滞后的要督促加快办理,对处置失当的要及时纠偏。
二、加强向生产企业穿透
要压实药品耗材生产企业公平合法诚信经营、维护正常价格秩序的第一责任,对案源已明确具体产品的评级处置,必须穿透到该产品的生产企业;对案源未明确具体产品的,应通过配送企业和医疗机构的举证追溯至具体产品及其生产企业。仅对配送企业进行处置,无法穿透至生产企业,以及按规定不纳入价格招采信用评价制度的案源,处置意见需经省级医疗保障局复核同意后办结。
三、加大信息披露力度
各省级医疗保障部门和医药集采机构均应在本单位门户网站醒目位置设置专栏,自2024年一季度起,向社会动态公告“特别严重”“严重”“中等”“一般”失信评定结果,并报国家医疗保障局(医药价格和招标采购指导中心)备案。国家医保局也将在门户网站价格招采信用评价专栏按季度公开有关情况。
四、拓展评定结果应用
在组织国家集采和省际联盟采购设置招采规则时,医疗保障部门应充分考虑评定结果因素,对“特别严重”及“严重”失信企业实行不同程度的禁入或约束,根据评级结果在续约时给予一定赋分。要强化信用评价与价格治理的协同联动,在一省确定失信产品价格虚高空间后,应及时通知他省予以关注。
来源:国家医保局官方网站
http://www.nhsa.gov.cn/art/2023/11/23/art_104_11554.html
6.(2023年11月24日)国家药监局关于发布YY0315—2023《钛及钛合金牙种植体》等13项医疗器械行业标准及7项医疗器械行业标准修改单的公告
YY0315—2023《钛及钛合金牙种植体》等13项医疗器械行业标准及7项医疗器械行业标准修改单已经审定通过,现予以公布。标准编号、名称、适用范围、修改单内容及实施日期见附件。
附件:
医疗器械行业标准信息表
YY/T0951—2015《干扰电治疗设备》医疗器械行业标准第1号修改单
YY/T0919—2014《无源外科植入物关节置换植入物膝关节置换植入物的专用要求》医疗器械行业标准第1号修改单
YY/T0966—2014《外科植入物金属材料纯钽》医疗器械行业标准第1号修改单
YY/T1426.1—2016《外科植入物全膝关节假体的磨损第1部分:载荷控制的磨损试验机的载荷和位移参数及相关的试验环境条件》医疗器械行业标准第1号修改单
YY/T1426.2—2016《外科植入物全膝关节假体的磨损第2部分:测量方法》医疗器械行业标准第1号修改单
YY/T1426.3—2017《外科植入物全膝关节假体的磨损第3部分:位移控制的磨损试验机的载荷和位移参数及相关的试验环境条件》医疗器械行业标准第1号修改单
YY/T1447—2016《外科植入物植入材料磷灰石形成能力的体外评估》医疗器械行业标准第1号修改单。
来源:国家药监局官方网站
https://www.nmpa.gov.cn/xxgk/ggtg/ylqxggtg/ylqxhybzhgg/20231124105920130.html
7.(2023年11月28日)国家药监局综合司公开征求《医疗器械临床试验检查要点及判定原则(征求意见稿)》意见
为落实《医疗器械注册与备案管理办法》《体外诊断试剂注册与备案管理办法》《医疗器械临床试验质量管理规范》,指导药品监督管理部门规范开展医疗器械临床试验监督检查工作,国家药监局组织制定了《医疗器械临床试验检查要点及判定原则(征求意见稿)》,现公开征求意见。
医疗器械临床试验检查目的主要是通过对注册申报资料与临床试验原始记录和基本文件的核对和/或实地确证,评价试验实施、数据记录和结果报告是否符合试验方案和医疗器械临床试验相关法规,确认医疗器械临床试验实施过程的规范性,核实相关申报资料的真实性、完整性、准确性和可溯源性,同时关注受试者权益和安全。
本检查要点适用于由国家药品监督管理局启动、由国家药品监督管理局食品药品审核查验中心组织实施的医疗器械临床试验现场检查。各省、自治区、直辖市药品监督管理部门对本行政区域内的临床试验现场检查参照本检查要点执行。
来源:国家药监局官方网站
https://www.nmpa.gov.cn/xxgk/zhqyj/zhqyjylqx/20231128171719195.html
(三)地方新规
1.(2023年11月8日)安徽省药品监督管理局关于发布实施《安徽省中药材标准》(2022年版)
根据《中华人民共和国药品管理法》及有关规定,我局组织完成了《安徽省中药材标准》(2022年版)编制工作,现予发布,自2023年12月1日起实施。
一、《安徽省中药材标准》(2022年版)是安徽省药品研制、生产、经营、使用和监督管理等遵循的法定技术标准。
二、自实施之日起,安徽省中药材同品种的原标准同时废止。如有同品种的国家药品标准颁布实施,我省制定的相应标准即行废止。
三、安徽省食品药品检验研究院负责《安徽省中药材标准》(2022年版)执行过程中的具体技术指导工作。
四、全省各级药品监督管理部门要做好标准的监督和实施,及时收集反馈相关意见和问题。各药品生产经营企业和使用单位应积极做好标准的执行工作,同时应持续研究完善质量标准,不断提高我省地方中药材的质量控制水平。
特此公告。
来源:安徽药监局官方网站
https://mpa.ah.gov.cn/zwgz/gsgg/121862811.html
2.(2023年11月10日)关于《江苏省药品安全责任约谈管理办法(征求意见稿)》公开征求意见的公告
为进一步强化药品(含医疗器械、化妆品,下同)安全监管,督促行政相对人落实药品安全主体责任,防范、控制和消除药品安全风险隐患,根据《中华人民共和国药品管理法》《中华人民共和国疫苗管理法》《医疗器械监督管理条例》《化妆品监督管理条例》等规定,结合本省实际,制定本办法。
全省各级承担药品监督管理职责的部门(以下称药品监督管理部门)在依法实施药品监督管理过程中实施责任约谈,适用本办法。
本办法所称责任约谈,是指药品监督管理部门依法约见行政相对人的法定代表人、主要负责人或者其他负责人员(以下统称被约谈人),指出问题、明确要求、督促整改的监督管理措施。
来源:江苏省药监局官方网站
http://da.jiangsu.gov.cn/art/2023/11/10/art_84622_11068107.html
3.(2023年11月10日)关于《江苏省药品监督管理行政处罚裁量权适用规则(修订草案征求意见稿)》公开征求意见的公告
为进一步规范药品、医疗器械和化妆品监督管理行政处罚行为,保障我省各级承担药品监督管理职责的部门(以下称药品监督管理部门)依法行使行政处罚裁量权,保护公民、法人或者其他组织的合法权益,根据《中华人民共和国行政处罚法》《中华人民共和国药品管理法》《中华人民共和国疫苗管理法》《医疗器械监督管理条例》《化妆品监督管理条例》《国务院办公厅关于进一步规范行政裁量权基准制定和管理工作的意见》《市场监管总局关于规范市场监督管理行政处罚裁量权的指导意见》等规定,结合我省实际,制定本规则。
江苏省各级药品监督管理部门行使药品监督管理领域行政处罚裁量权,适用本规则。法律、法规、规章对适用行政处罚裁量另有规定的,从其规定。
本规则所称行政处罚裁量权,是指药品监督管理部门在实施行政处罚时,根据法律、法规、规章的规定,综合考虑违法行为的事实、性质、情节、社会危害程度以及当事人主观过错等因素,决定是否给予行政处罚、给予行政处罚的种类和幅度的权限。
来源:江苏省药监局官方网站
http://da.jiangsu.gov.cn/art/2023/11/10/art_84622_11068135.html
4.(2023年11月20日)关于印发《上海市遏制微生物耐药行动计划(2022-2025年)实施方案》的通知
为积极应对微生物耐药带来的挑战,贯彻落实《中华人民共和国生物安全法》《关于印发遏制微生物耐药国家行动计划(2022-2025年)的通知》(国卫医函〔2022〕185号)要求,遏制微生物耐药,更好地保护人民健康,结合我市实际,制定本实施方案。
坚持预防为主、防治结合、综合施策的原则,聚焦微生物耐药存在的突出问题,创新体制机制,有效控制人类和动物源主要病原微生物耐药形势。到2025年,本市应对微生物耐药治理体系基本完善,公众微生物耐药防控相关健康素养大幅提升,医疗卫生和动物卫生专业人员微生物耐药防控能力显著提高,人类和动物抗微生物药物应用和耐药监测评价体系更加健全,抗微生物药物合理应用水平进一步提升,微生物耐药防控的科学技术研究进一步加强、区域间交流与合作深入推进。
来源:上海卫健委官方网站
https://wsjkw.sh.gov.cn/yzgl4/20231120/6862c3efa285423da68953d0e81d8335.html
二、生物医药案例
1.【国外】美国倍而达公司起诉益方生物侵犯化合物商业秘密
美国倍而达(BetaPharma,Inc.)在美国新泽西地区法院对益方生物、YuehengJiang(江岳恒)、WanshengJerryLiu和FoxRothschild,LLP提起了民事诉讼。美国倍而达提出,益方生物的申请号为CN201910491253.6的专利申请存在联邦《保护商业秘密法》和《新泽西州商业秘密法》项下的商业秘密盗窃,以及与美国倍而达声称的保密和专有的涉诉化合物相关的商业秘密盗用、对于违反受托义务的协助和教唆、不当得利、不正当竞争、民事共谋等情况。
美国倍而达据此请求法院,要求赔偿其损失,并要求益方生物将包括涉案专利申请在内的相关专利及专利申请的权利人变更登记为原告。
关键词:商业秘密;化合物专利;益方生物
2.【国外】生物医药公司NanoStringTechnologies侵犯Prognosys公司的专利
美国特拉华州地方法院陪审团认定生物医药公司NanoStringTechnologies(以下简称NanoString)的GeoMx数字空间轮廓仪以及用于RNA和蛋白质检测的相关仪器、试剂和服务故意侵犯了Prognosys公司拥有并独家授权给基因组生物技术公司10xGenomics(以下简称10x)的全部七项专利,并由此裁决NanoString承担从2021年5月6日至2023年10月13日因销售GeoMx产品导致的超过3100万美元的损害赔偿金。
在本案中10x主张的专利包括:10,472,669号美国专利、10,961,566号美国专利、10,983,113号美国专利、10,996,219号美国专利、11,001,878号美国专利、11,008,607号美国专利和11,293,917号美国专利。
关键词:医疗器械;专利侵权;基因
3.【国外】英国法院驳回雅培针对德康医疗专利侵权诉讼
Dexcom公司(德康医疗)成立于1999年,是一家美国医疗器械公司,致力于研发针对个人用户的持续检测血糖CGM(ContinuousGlucoseMonitoring)的产品。Abbott公司成立于1888年,中文名雅培,总部位于美国芝加哥,是一家全球医疗健康公司。
审判涉及雅培的专利EP2549918(简称EP918)。雅培指控Dexcom的G7Applicator侵犯了其专利权,而Dexcom则基于添加物质反诉该专利无效。然而,高等法院已经驳回了雅培的侵权主张,并认定该专利有效(案件编号:HP-2021-000025)。2022年秋,欧洲专利局上诉委员会也维持了经修正的专利EP918(案件编号:T0629/19)。
关键词:专利侵权;医疗器械;连续血糖监测设备
4.【国外】美国生物制药公司再生元起诉Celltrion专利侵权
美国生物制药公司Regeneron(再生元)于11月8日在美国西弗吉尼亚州北区地方法院对韩国生物制药公司Celltrion提起诉讼,指控Celltrion侵犯了38项专利,其依据是Celltrion根据BPCIA提交了CT-P42的aBLA(简化生物制剂许可申请),这是一种拟议的EYLEA(aflibercept,阿柏西普,用于眼部疾病)生物仿制药,而且celltrion提供了关于该产品的商业营销通知。
再生元在起诉书中声称:1、Celltrion的CT-P42的使用侵犯了八项专利,这些专利通常涉及按照特定的计量表使用阿柏西普的方法,以治疗某些血管性眼病和/或已被确定具有某些多态性的患者;2、Celltrion的CT-P42配方侵犯了四项专利,这些专利通常涉及阿柏西普的稳定配方;3、Celltrion生产CT-P42的工艺侵犯了或导致CT-P42侵犯了二十五项专利;4、CT-P42 的拟议容器封闭系统侵犯了一项专利。
再生元要求法院判决:1、Celltrion侵犯了所主张的专利,要求赔偿损失、费用和成本;2、宣布该案件为例外(exceptional);3、判决Celltrion故意侵权并增加损害赔偿金;4、包括初步和永久禁令在内的衡平法救济。另外,再生元还要求一项关于损害赔偿金核算的裁决。
关键词:生物药;专利侵权;阿柏西普
5.【国外】艾伯维向5家生物类似药生产商起诉Rinvoq专利权侵权
在21日向特拉华州联邦法院提起的诉讼中,艾伯维指控山德士(Sandoz)、Hetero Labs、Aurobindo Pharma、Intas Pharmaceuticals和Sun Pharmaceuticals等五家全球知名仿制药制药商侵犯Rinvoq数十项专利权,并指控这五家制药商在Rinvoq专利期内试图销售该药物的假冒版本。
Rinvoq是艾伯维研发的一款选择性口服JAK1抑制剂,于2019年8月获FDA 批准上市,用于用于治疗对甲氨蝶呤应答不足或不耐受的中度至重度活动性类风湿性关节炎成人患者。
关键词:专利侵权;生物类似药;JAK1抑制剂
6.【国外】欧洲专利局撤销美国生物技术公司Moderna一项专利
在美国生物技术公司Moderna与德国生物科技公司BioNTech之间关于mRNA专利的泛欧洲争端中,欧洲专利局异议部门撤销了专利持有者Moderna的一项专利。
Moderna在德国、英国、荷兰、比利时和爱尔兰等多个国家起诉了总部位于美因茨的竞争对手BioNTech。这场争端围绕着Moderna的两项专利EP 3 590 949 B1(以下简称专利EP 949)和EP 3 718 565 B1(以下简称专利EP 565)展开,这两项专利分别保护“含有n1-甲基-假尿嘧啶的核糖核酸及其用途”和“呼吸道病毒疫苗”。
目前,欧洲专利局的异议部门已撤销了专利EP 565,原因是增加了新的内容。
关键词:专利纠纷;mRNA疫苗;欧洲专利局
本文作者 | 医药健康部,王浩然编辑,陈斌寅审核。

BOSS&YOUNG
声明
本文仅代表作者本人观点,不得视为邦信阳律师事务所及律师出具的正式法律意见或建议。如需转载或引用本文的任何内容,请完整注明作者及出处等信息。如您有意就相关议题进一步交流或探讨,欢迎与我们联系。
专业
高效
富有创造力
